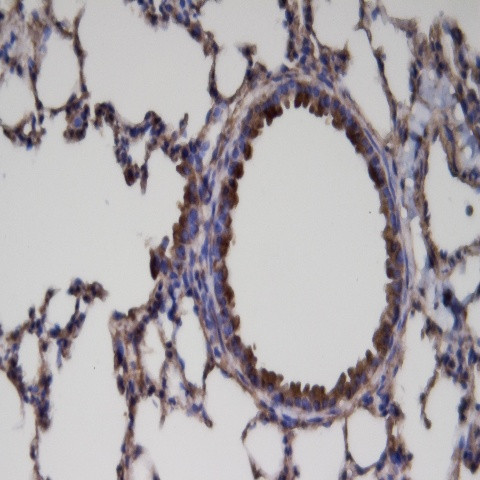
ER81 Antibody in Immunohistochemistry (Paraffin) (IHC (P))

Search
AbboMax
ER81 Polyclonal Antibody
{{$productOrderCtrl.translations['antibody.pdp.commerceCard.promotion.promotions']}}
{{$productOrderCtrl.translations['antibody.pdp.commerceCard.promotion.viewpromo']}}
{{$productOrderCtrl.translations['antibody.pdp.commerceCard.promotion.promocode']}}: {{promo.promoCode}} {{promo.promoTitle}} {{promo.promoDescription}}. {{$productOrderCtrl.translations['antibody.pdp.commerceCard.promotion.learnmore']}}
图: 1 / 2
ER81 Antibody (602-930) in IHC (P)


产品信息
602-930
种属反应
宿主/亚型
分类
类型
抗原
偶联物
形式
浓度
规格
纯化类型
保存液
内含物
保存条件
运输条件
产品详细信息
Positive control: Mouse brain
Cellular location: Nuclear, Cytoplasmic.
靶标信息
ETV1: ets variant gene 1. Several members of the Ets gene family encode sequence-specific DNA binding proteins that recognize DNA sequences with a centrally located 5'-GGAA-3' element. All of the Ets proteins recognize the same central core sequence but each protein interacts with unique sequences that flank this core. ER81 (also designated ETV1) binds the motif 5'-CGGAA/T-3'. ER81 is highly expressed in brain, testis, lung and heart. ER81 is also moderately expressed in spleen, pancreas, colon and small intestine. During development, ER81 displays a unique expression patterns which suggests that this transcriptional factor might play an important role in organogenesis. ERK-1 activates ER81 transcriptional activity while MAPKAP kinase 2 inhibits ER81.
仅用于科研。不用于诊断过程。未经明确授权不得转售。
篇参考文献 (0)
生物信息学
蛋白别名: DKFZp781L0674; ets related protein 81; ets translocation variant; ETS translocation variant 1; ets variant gene 1; Ets-related protein 81; MGC104699; MGC120533; MGC120534; unnamed protein product
基因别名: ER81; Etsrp81; ETV1
UniProt ID: (Human) P50549, (Mouse) P41164
Entrez Gene ID: (Human) 2115, (Rat) 362733, (Mouse) 14009